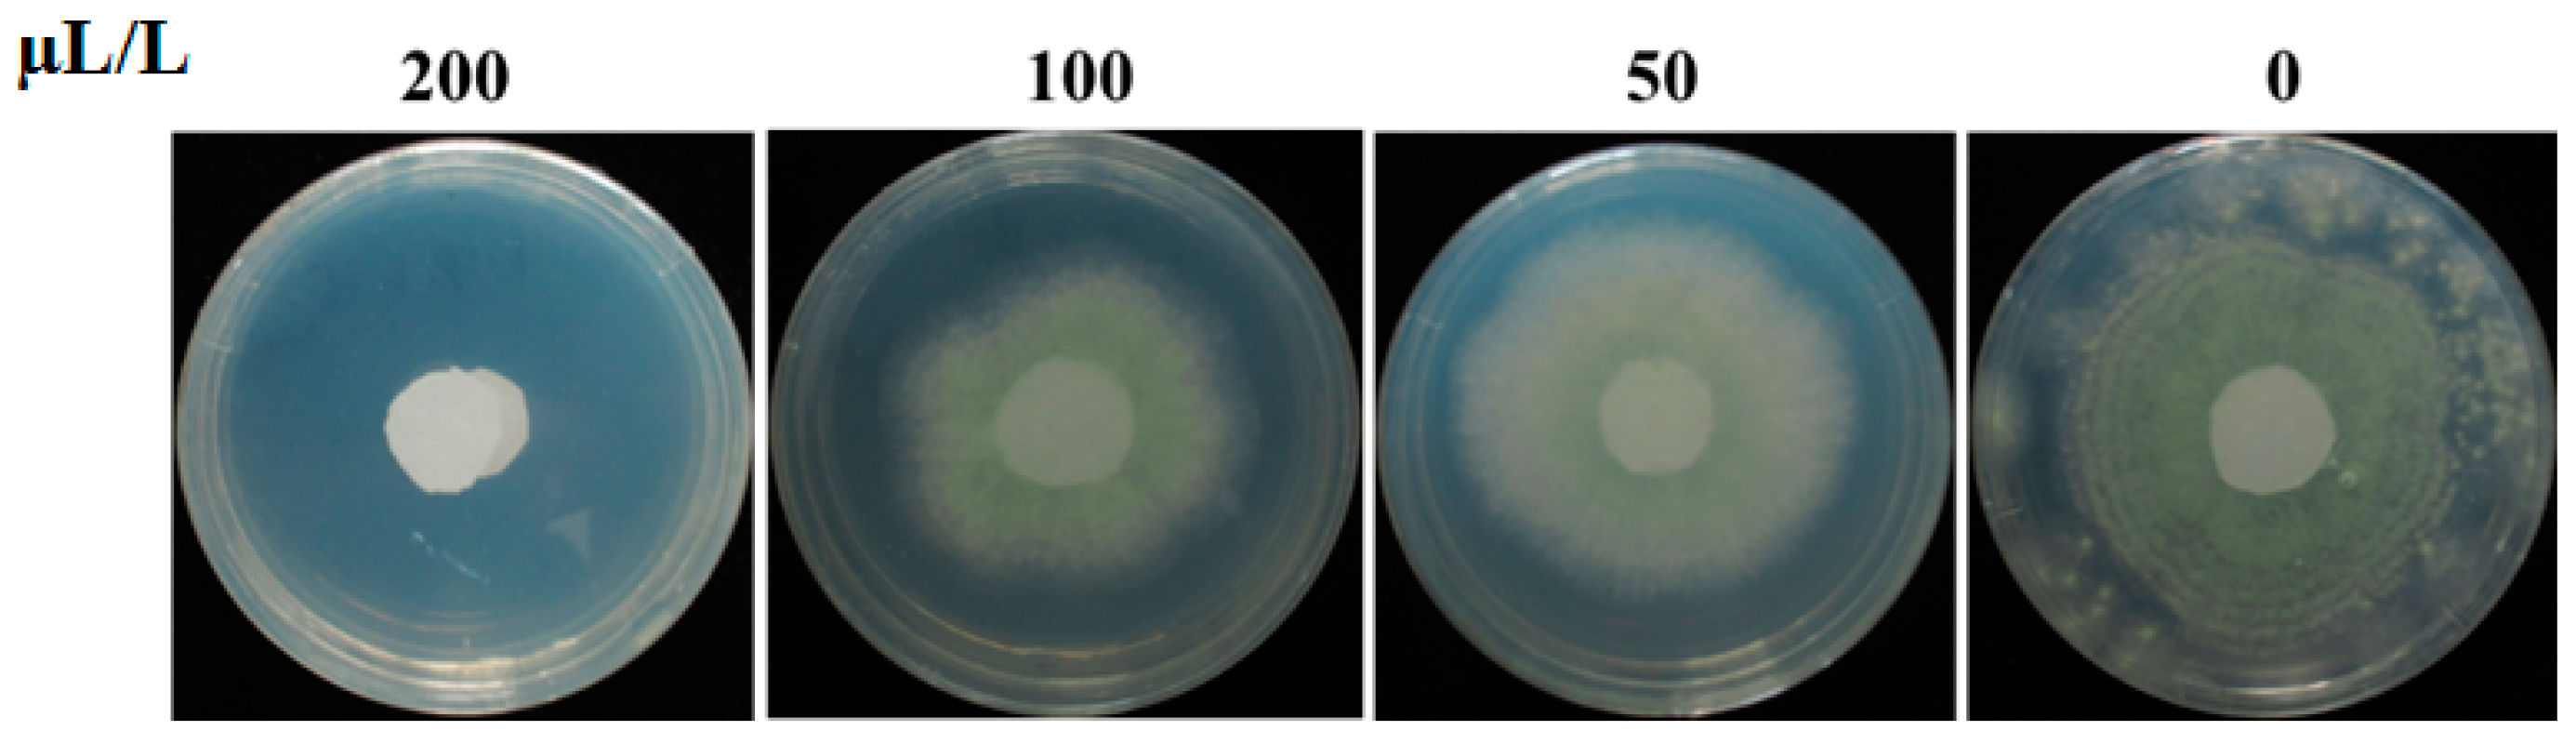
Toxins 14 00788 g006 Toxins 14 00788 g006

The Inhibitory Effect of Pseudomonas stutzeri YM6 on Aspergillus flavus Growth and Aflatoxins Production by the Production of Volatile Dimethyl Trisulfide
Abstract
1. Introduction
2. Results
2.1. Identification of Strain YM6
2.2. Inhibition of Pseudomonas stutzeri YM6 against A. flavus
2.3. Biocontrol Activity of YM6 against A. flavus and Aflatoxins in Peanut and Maize during Storage
2.4. Analysis of A. flavus Cell Structure Affected by YM6
2.5. Chemical Identification of Volatiles Produced by the YM6 Strain
2.6. Minimal Inhibitory Concentration of DMTS against A. flavus
3. Discussion
4. Materials and Methods
4.1. Microbes and Plants
4.2. DNA Extraction and Phylogenic Analysis
4.3. Inhibitory Effect of YM6 on Mycelial Growth of A. flavus
4.4. Inhibitory Effect of YM6 on the Conidia Germination of A. flavus
4.5. Biocontrol Activity of YM6 against A. flavus and Aflatoxins in Peanut and Maize
4.6. Structural analysis of A. flavus Treated by Volatile from YM6
4.7. Identification of Volatiles from the Strain YM6
4.8. Inhibition Effect of DMTS on A. flavus
4.9. Data Analysis
Author Contributions
Funding
Institutional Review Board Statement
Informed Consent Statement
Data Availability Statement
Conflicts of Interest
References
- Alshannaq, A.F.; Gibbons, J.G.; Lee, M.K.; Han, K.H.; Hong, S.B.; Yu, J.H. Controlling aflatoxin contamination and propagation of Aspergillus flavus by a soy-fermenting Aspergillus oryzae strain. Sci. Rep. 2018, 8, 16871. [Google Scholar] [CrossRef] [PubMed]
- Waliyar, F.; Umeh, V.; Traore, A.; Osiru, M.; Ntare, B.; Diarra, B.; Kodio, O.; Kumar, K.V.K.; Sudini, H. Prevalence and distribution of aflatoxin contamination in groundnut (Arachis hypogaea L.) in Mali, West Africa. Crop. Prot. 2015, 70, 1–7. [Google Scholar] [CrossRef]
- Ma, F.; Cai, X.F.; Mao, J.; Yu, L.; Li, P.W. Adsorptive removal of aflatoxin B1 from vegetable oils via novel adsorbents derived from a metal-organic framework. J. Hazard. Mater. 2021, 412, 125170. [Google Scholar] [CrossRef] [PubMed]
- Asters, M.C.; Williams, W.P.; Perkins, A.D.; Mylroie, J.E.; Windham, G.L.; Shan, X. Relating significance and relations of differentially expressed genes in response to Aspergillus flavus infection in maize. Sci. Rep. 2014, 4, 4815. [Google Scholar] [CrossRef]
- Gong, A.D.; Wu, N.N.; Kong, X.W.; Zhang, Y.M.; Hu, M.J.; Gong, S.J.; Dong, F.Y.; Wang, J.H.; Zhao, Z.Y.; Liao, Y.C. Inhibitory effect of volatiles emitted from Alcaligenes faecalis N1-4 on Aspergillus flavus and aflatoxins in storage. Front. Microbiol. 2019, 10, 1419. [Google Scholar] [CrossRef]
- Pandey, M.K.; Kumar, R.; Pandey, A.K.; Soni, P.; Gangurde, S.S.; Sudini, H.K.; Fountain, J.C.; Liao, B.; Desmae, H.; Okori, P.; et al. Mitigating aflatoxin contamination in groundnut through a combination of genetic resistance and post-harvest management practices. Toxins 2019, 11, 315. [Google Scholar] [CrossRef]
- Mitchell, N.J.; Bowers, E.; Hurburgh, C.; Wu, F. Potential economic losses to the USA corn industry from aflatoxin contamination. Food Addit. Contam. Part A 2016, 33, 540–550. [Google Scholar] [CrossRef]
- Marchese, S.; Polo, A.; Ariano, A.; Velotto, S.; Costantini, S.; Severino, L. Aflatoxin B1, and M1: Biological properties and their involvement in cancer development. Toxins 2018, 10, 214. [Google Scholar] [CrossRef]
- Chen, J.G.; Egner, P.A.; Ng, D.; Jacobson, L.P.; Muñoz, A.; Zhu, Y.R.; Qian, G.S.; Wu, F.; Yuan, J.M.; Groopman, J.D. Reduced aflatoxin exposure presages decline in liver cancer mortality in an endemic region of China. Cancer Prev. Res. 2013, 6, 1038–1045. [Google Scholar] [CrossRef]
- East African Community (EAC). East African Standards: Maize Grains–Specification; EAC: Dar es Salaam, Tanzania, 2011; Available online: https://law.resource.org/pub/eac/ibr/eas.2.2011.html (accessed on 2011).
- European Commission (EC). Guidance Document for Competent Authorities for the Control of Compliance with EU Legislation on Aflatoxins; Regulation No. 1152/2009; EC: Brussels, Belgium, 2010; Available online: https://food.ec.europa.eu/system/files/2021-05/cs_contaminants_catalogue_alfatoxins_guidance-2010_en.pdf (accessed on 27 November 2010).
- Hua, H.J.; Xing, F.G.; Selvaraj, J.N.; Wang, Y.; Zhao, Y.J.; Zhou, L.; Liu, X.; Liu, Y. Inhibitory effect of essential oils on Aspergillus ochraceus growth and ochratoxin A production. PLoS ONE 2014, 9, e108285. [Google Scholar] [CrossRef]
- Tran-Dinh, N.; Pitt, J.I.; Markwell, P.J. Selection of non-toxigenic strains of Aspergillus flavus for biocontrol of aflatoxins in maize in Thailand. Biocontrol. Sci. Technol. 2014, 24, 652–661. [Google Scholar] [CrossRef]
- Kong, Q.; Shan, S.H.; Liu, Q.Z.; Wang, X.D.; Yu, F.T. Biocontrol of Aspergillus flavus on peanut kernels by use of a strain of marine Bacillus megaterium. Int. J. Food Microbiol. 2010, 139, 31–35. [Google Scholar] [CrossRef] [PubMed]
- Chen, Y.J.; Kong, Q.; Liang, Y. Three newly identified peptides from Bacillus megaterium strongly inhibit the growth and aflatoxin B1 production of Aspergillus flavus. Food Control 2019, 95, 41–49. [Google Scholar] [CrossRef]
- Farzaneh, M.; Shi, Z.Q.; Ahmadzadeh, M.; Hu, L.B.; Ghassempour, A. Inhibition of the Aspergillus flavus growth and aflatoxin B1 contamination on pistachio nut by fengycin and surfactin-producing Bacillus subtilis UTBSP1. Plant Pathol. J. 2016, 32, 209. [Google Scholar] [CrossRef]
- Passone, M.A.; Etcheverry, M. Antifungal impact of volatile fractions of Peumus boldus and Lippia turbinata on Aspergillus section Flavi and residual levels of these oils in irradiated peanut. Int. J. Food Microbiol. 2014, 168, 17–23. [Google Scholar] [CrossRef]
- Gong, A.D.; Sun, G.J.; Zhao, Z.Y.; Liao, Y.C.; Zhang, J.B. Staphylococcus saprophyticus L-38 produces volatile 3, 3-dimethyl-1, 2-epoxybutane with strong inhibitory activity against Aspergillus flavus germination and aflatoxin production. World Mycotoxin J. 2020, 13, 247–258. [Google Scholar] [CrossRef]
- Gong, A.D.; Wang, G.Z.; Sun, Y.K.; Song, M.G.; Dimuna, C.; Gao, Z.; Wang, H.L.; Yang, P. Dual activity of Serratia marcescens Pt-3 in phosphate-solubilizing and production of anti-fungal volatiles. BMC Microbiol. 2022, 22, 1–11. [Google Scholar] [CrossRef]
- Gong, A.D.; Dong, F.Y.; Hu, M.J.; Kong, X.W.; Wei, F.F.; Gong, S.J.; Zhang, Y.M.; Zhang, J.B.; Wu, A.B.; Liao, Y.C. Antifungal activity of volatile emitted from Enterobacter asburiae Vt-7 against Aspergillus flavus and aflatoxins in peanuts during storage. Food Control 2019, 106, 106718. [Google Scholar] [CrossRef]
- Gong, A.D.; Li, H.P.; Yuan, Q.S.; Song, X.S.; Yao, W.; He, W.J.; Zhang, J.B.; Liao, Y.C. Antagonistic mechanism of iturin A and plipastatin A from Bacillus amyloliquefaciens S76-3 from wheat spikes against Fusarium graminearum. PLoS ONE 2015, 10, e0116871. [Google Scholar] [CrossRef]
- Ahima, J.; Zhang, X.Y.; Yang, Q.Y.; Zhao, L.N.; Tibiru, A.M.; Zhang, H.Y. Biocontrol activity of Rhodotorula mucilaginosa combined with salicylic acid against Penicillium digitatum infection in oranges. Biol. Control 2019, 135, 23–32. [Google Scholar] [CrossRef]
- Yang, J.H.; Zhang, W.W.; Zhuang, Y.Q.; Xiao, T. Biocontrol activities of bacteria from cowdung against the rice sheath blight pathogen. J. Plant Dis. Prot. 2017, 124, 131–141. [Google Scholar] [CrossRef]
- Noreen, R.; Ali, S.A.; Hasan, K.A.; Sultana, V.; Ara, J.; Ehteshamul-Haque, S. Evaluation of biocontrol potential of epiphytic yeast against postharvest Penicillium digitatum rot of stored Kinnow fruit (Citrus reticulata) and their effect on its physiochemical properties. Postharvest Biol. Technol. 2019, 148, 38–48. [Google Scholar]
- Afsharmanesh, H.; Ahmadzadeh, M.; Javan-Nikkhah, M.; Behboudi, K. Improvement in biocontrol activity of Bacillus subtilis UTB1 against Aspergillus flavus using gamma-irradiation. Crop. Prot. 2014, 60, 83–92. [Google Scholar] [CrossRef]
- Gong, A.D.; Li, H.P.; Shen, L.; Zhang, J.B.; Wu, A.B.; He, W.J.; Yuan, Q.S.; He, J.D.; Liao, Y.C. The Shewanella algae strain YM8 produces volatiles with strong inhibition activity against Aspergillus pathogens and aflatoxins. Front. Microbiol. 2015, 6, 1091. [Google Scholar] [CrossRef] [PubMed]
- Yang, M.G.; Lu, L.F.; Pang, J.; Hu, Y.L.; Guo, Q.B.; Li, Z.J.; Wu, S.F.; Liu, H.H.; Wang, C.L. Biocontrol activity of volatile organic compounds from Streptomyces alboflavus TD-1 against Aspergillus flavus growth and aflatoxin production. J. Microbiol. 2019, 57, 396–404. [Google Scholar] [CrossRef] [PubMed]
- Lyu, A.; Yang, L.; Wu, M.D.; Zhang, J.; Li, G.Q. High efficacy of the volatile organic compounds of Streptomyces yanglinensis 3-10 in suppression of Aspergillus contamination on peanut kernels. Front. Microbiol. 2020, 11, 142. [Google Scholar] [CrossRef]
- Mannaa, M.; Oh, J.Y.; Kim, K.D. Biocontrol activity of volatile-producing Bacillus megaterium and Pseudomonas protegens against Aspergillus flavus and aflatoxin production on stored rice grains. Mycobiology 2017, 45, 213–219. [Google Scholar] [CrossRef]
- Tang, L.H.; Mo, J.Y.; Guo, T.X.; Huang, S.P.; Li, Q.L.; Ning, P.; Hsiang, T. In vitro antifungal activity of dimethyl trisulfide against Colletotrichum gloeosporioides from mango. World J. Microbiol. Biotechnol. 2020, 36, 4. [Google Scholar] [CrossRef]
- Zuo, C.W.; Zhang, W.N.; Chen, Z.J.; Chen, B.H.; Huang, Y.H. RNA sequencing reveals that endoplasmic reticulum stress and disruption of membrane integrity underlie dimethyl trisulfide toxicity against Fusarium oxysporum f. sp. cubense tropical race 4. Front. Microbiol. 2017, 8, 1365. [Google Scholar] [CrossRef]
- Myrta, A.; Sasanelli, N.; Dongiovanni, C.; Santori, A. Control of the root-knot nematode Meloidogyne incognita by dimethyl disulfide (DMDS) applied in drip irrigation on melon and tomato in Apulia and Basilicata (Italy). Acta Hortic. 2014, 1044, 401–404. [Google Scholar]
- Papazlatani, C.; Rousidou, C.; Katsoula, A.; Kolyvas, M.; Genitsaris, S.; Papadopoulou, K.; Karpouzas, D.G. Assessment of the impact of the fumigant dimethyl disulfide on the dynamics of major fungal plant pathogens in greenhouse soils. Eur. J. Plant Pathol. 2016, 146, 391–400. [Google Scholar] [CrossRef]
- Zhang, H.; Mallik, A.; Zeng, R.S. Control of Panama disease of banana by rotating and intercropping with Chinese chive (Allium tuberosum Rottler): Role of plant volatiles. J. Chem. Ecol. 2013, 39, 243–252. [Google Scholar] [CrossRef] [PubMed]
- Zhang, Q.H.; Yang, L.; Zhang, J.; Wu, M.D.; Chen, W.D.; Jiang, D.H.; Li, G.Q. Production of anti-fungal volatiles by non-pathogenic Fusarium oxysporum and its efficacy in suppression of Verticillium wilt of cotton. Plant Soil. 2015, 392, 101–114. [Google Scholar] [CrossRef]

| Value of Water Activity | Treatment | Aflatoxin Concentration/ppb | |||
|---|---|---|---|---|---|
| AFB1 | AFB2 | Total | |||
| Peanut | 0.740 | Control | 85.41 ± 3.21 | 14.08 ± 0.76 | 99.49 |
| YM6 | — | — | — | ||
| 0.859 | Control | 299.36 ± 17.55 | 30.81 ± 7.83 | 330.17 | |
| YM6 | — | — | — | ||
| 0.923 | Control | 1575.19 ± 67.32 | 192.42 ± 9.22 | 1767.61 | |
| YM6 | 3.74 ± 0.24 * | — | 3.74 | ||
| Maize | 0.785 | Control | 24.92 ± 2.60 | 2.17 ± 0.13 | 27.09 |
| YM6 | — | — | — | ||
| 0.866 | Control | 156.62 ± 4.63 | 21.77 ± 1.56 | 178.39 | |
| YM6 | — | — | — | ||
| 0.934 | Control | 402.31 ± 9.32 | 63.82 ± 4.35 | 466.13 | |
| YM6 | — | — | — | ||
| No. | Compounds | Retention Time/min | Peak Area /% a | Similarity /% b | Mass /m·z−1 |
|---|---|---|---|---|---|
| 1 | Dimethyl trisulfide | 11.238 | 13.877 | 90 | 125.963 |
| 2 | 1-(trimethylsilyl)-1-propyne | 14.797 | 7.451 | 52 | 112.071 |
| 3 | Oxalic acid, isobutyl pentadecyl ester | 16.777 | 0.962 | 72 | 356.293 |
| 4 | 1-methyl-2-pentyl- Cyclohexane | 17.131 | 0.122 | 76 | 168.188 |
| 5 | Undecane | 18.785 | 0.200 | 93 | 156.188 |
| 6 | 3,5-dimethyl- Isoxazole | 30.447 | 0.884 | 72 | 97.053 |
| 7 | 2,4,4,6,6,8,8-Heptamethyl-2-nonene | 30.824 | 0.485 | 60 | 224.252 |
| 8 | Butylated hydroxytoluene | 37.084 | 0.992 | 97 | 220.183 |
Publisher’s Note: MDPI stays neutral with regard to jurisdictional claims in published maps and institutional affiliations. |
© 2022 by the authors. Licensee MDPI, Basel, Switzerland. This article is an open access article distributed under the terms and conditions of the Creative Commons Attribution (CC BY) license (https://creativecommons.org/licenses/by/4.0/).
Share and Cite
Gong, A.-D.; Lei, Y.-Y.; He, W.-J.; Liao, Y.-C.; Ma, L.; Zhang, T.-T.; Zhang, J.-B. The Inhibitory Effect of Pseudomonas stutzeri YM6 on Aspergillus flavus Growth and Aflatoxins Production by the Production of Volatile Dimethyl Trisulfide. Toxins 2022, 14, 788. https://doi.org/10.3390/toxins14110788
Gong A-D, Lei Y-Y, He W-J, Liao Y-C, Ma L, Zhang T-T, Zhang J-B. The Inhibitory Effect of Pseudomonas stutzeri YM6 on Aspergillus flavus Growth and Aflatoxins Production by the Production of Volatile Dimethyl Trisulfide. Toxins. 2022; 14(11):788. https://doi.org/10.3390/toxins14110788
Chicago/Turabian StyleGong, An-Dong, Yin-Yu Lei, Wei-Jie He, Yu-Cai Liao, Ling Ma, Tian-Tian Zhang, and Jing-Bo Zhang. 2022. "The Inhibitory Effect of Pseudomonas stutzeri YM6 on Aspergillus flavus Growth and Aflatoxins Production by the Production of Volatile Dimethyl Trisulfide" Toxins 14, no. 11: 788. https://doi.org/10.3390/toxins14110788
APA StyleGong, A.-D., Lei, Y.-Y., He, W.-J., Liao, Y.-C., Ma, L., Zhang, T.-T., & Zhang, J.-B. (2022). The Inhibitory Effect of Pseudomonas stutzeri YM6 on Aspergillus flavus Growth and Aflatoxins Production by the Production of Volatile Dimethyl Trisulfide. Toxins, 14(11), 788. https://doi.org/10.3390/toxins14110788

